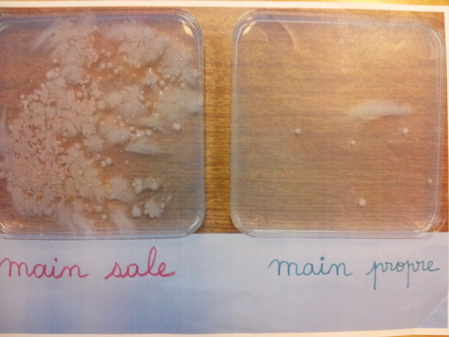
Lavage des mains ... Lavage des mains ...

Dans le cadre de notre projet d'année "Bien grandir", nous nous sommes intéressés à un sujet traitant de l'hygiène : "le lavage des mains".
Tour d'abord, nous avons commencé par une expérience en posant une main sale dans une boîte de Petri, et une main propre dans une autre boîte.
Après quelques jours, nous avons comparé les 2 boîtes... aïe aïe les microbes de la main sale ne sont vraiment pas beaux!
Alors aujourd'hui, la maman de Lola, qui est infirmière, est venue nous parler du lavage des mains : pourquoi, quand, comment se laver les mains ?
Savonner les paumes, le dessus des mains, entre les doigts, autour des pouces et des poignets. Il faut que ça mousse !
Un grand merci à la maman de Lola pour son intervention et tous ses conseils pour le lavage des mains !

Accueil

Accueil